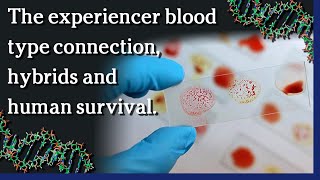
Watch April 28, 2021 - The experiencer blood type connection,  hybrids and  human survival.

TOPICS:
We broke through 172,000 subscribers!
COVID-19 updates
- Some good news in United States…CDC reports 232M COVID-19 vaccinations to date.
- 54% of Americans over 18 have had at least 1 shot.
- Number of US COVID deaths more than 600,000
- India performing mass cremations as cases rise to more than 300,000 new cases per day
- US lifts pause on use of J&J vaccine
- COVID-19 can cause blood clots and is labelled a “viral thrombotic fever”
Blood
- Rh factor is a protein found on the surface
- Rh+ is the most common blood type.
- MUFON survey found that 33% of respondents were RH negative.
MUFON member and experiencer Denise Stoner hypnosis recollection by Kathleen Marden
- “The entities are not showing themselves”
- “they don’t want to frighten us…humans have been misinformed”
- “they are very concerned about our use of nuclear weapons”
New Book and Live Panel:
Alan Steinfeld has a new book “Making Contact”
https://www.amazon.com/s?k=making+contact+alan+steinfeld&i=stripbooks&crid=193SFW2PYNI6O&sprefix=making+con%2Cstripbooks%2C238&ref=nb_sb_ss_ts-doa-p_2_10Making Contact Panel
https://portaltoascension.org/event/making-contact/Only about 15% of the general human population is RH-negative. Everyone else is RH-positive. A Mutual UFO Network survey of blood types among UFO abductees found 33% of experiencers are RH-negative, higher than the general population. And some of those experiencers think other intelligences are still manipulating genes in humans to help us survive.
Tune In LIVE Earthfiles YouTube Channel broadcast on Wednesday, April 28th, 2021, at 6:30 PM Pacific / 9:30 PM Eastern — and all other time zones around the world — for insights about hybrids and human survival from a case of missing time.
====
Books mentioned:
CAPTURED! The Betty and Barney Hill UFO Experience
Stanton Friedman and Katheleen Marden
The Alien Abduction File
Kathleen Marden and Denise Stoner
=====
Antarctica: Alien Secrets Beneath the Ice
New documentary now available:
https://www.earthfiles.com/antarctica/Contact Linda directly:
Email:
[email protected]Secure ProtonMail:
[email protected]Mail:
Linda Moulton Howe
P. O. Box 21843
Albuquerque, NM 87154
**Please "Like" and "Subscribe"**
**Please "Like" and "Subscribe"**
— For more incredible reports on Science, Real X-Files, the Environment and so much more, please visit my site
https://www.earthfiles.com/— Be sure to subscribe to this Earthfiles Channel the official channel for Linda Moulton Howe
https://www.youtube.com/Earthfiles.— To stay up to date on everything Earthfiles, follow me on FaceBook @EarthfilesNews and Twitter @Earthfiles.
To purchase books and merchandise from Linda Moulton Howe, be sure to only shop at her official Earthfiles store at
https://www.earthfiles.com/earthfiles-shop/— Countdown Clock Piano Music: Ashot Danielyan, Composer:
https://www.pond5.com/stock-music/100990900/emotional-piano-melancholic-drama.htmlFor international translations, please see closed caption video at end of each recorded broadcast. If [CC] is not working, try again later.

Sign in to UFO Slice
Sign in to UFO Slice Mark ALL Videos as Watched
Mark ALL Videos as Watched Mark ALL Videos as Un-Watched
Mark ALL Videos as Un-Watched